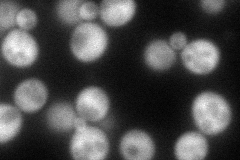
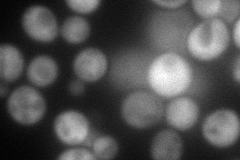
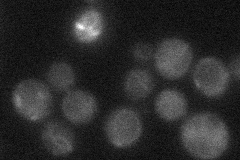
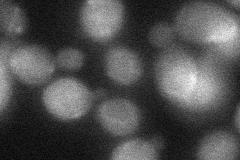
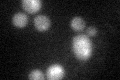
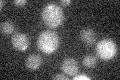

View description
Sporulation-specific homolog of the yeast CDC3/10/11/12 family of bud neck microfilament genes; meiotic septin expressed at high levels during meiotic divisions and ascospore formation
Localization:
Intensity:
Fold change:
Significance:
-
C’ GFP library in SD

below threshold15.81 -
N' NOP1pr-GFP in SD
cytosol88.9229 -
N' TEF2pr-mCherry in SD
cytosol115.075 -
N' NATIVEpr-GFP in SD
below threshold16.4983 -
N' TEF2pr-VC and Cyto-VN in SD
cytosol,punctate39.9366 -
C’ GFP library in SD+DTT
cytosol16.621.05No -
C’ GFP library in SD+H2O2

cytosol15.820.99No -
C’ GFP library in Starvation Media
cytosol14.220.89No -
C’ GFP library on the background of Pup2-DaMP

below threshold -
C’ GFP library on the background of CCT mutant

below threshold15.98671.01041No
